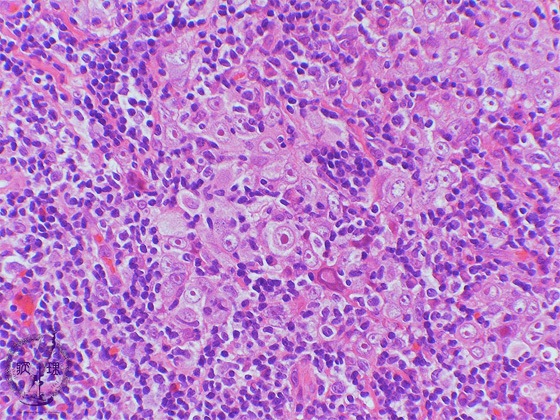

- 4.Upper airway tract and larynx
- ★(4)Nasopharyngeal carcinoma (lymphoepithelioma)
Microscopic view (high power view): Nasopharyngeal undifferentiated carcinoma is characterized by round to oval vesicular nuclei with large central nucleoli (arrow). Such undifferentiated carcinoma may arise in the middle pharynx, salivary glands, stomach and or thymus.
Click the image to see the enlarged image.